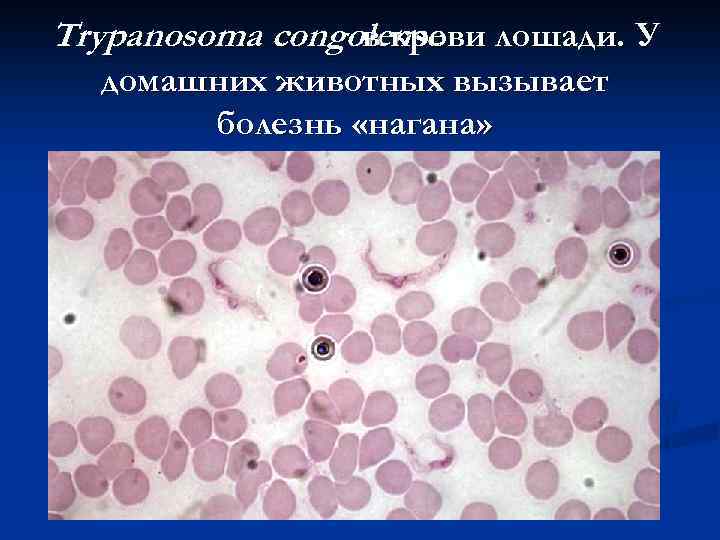
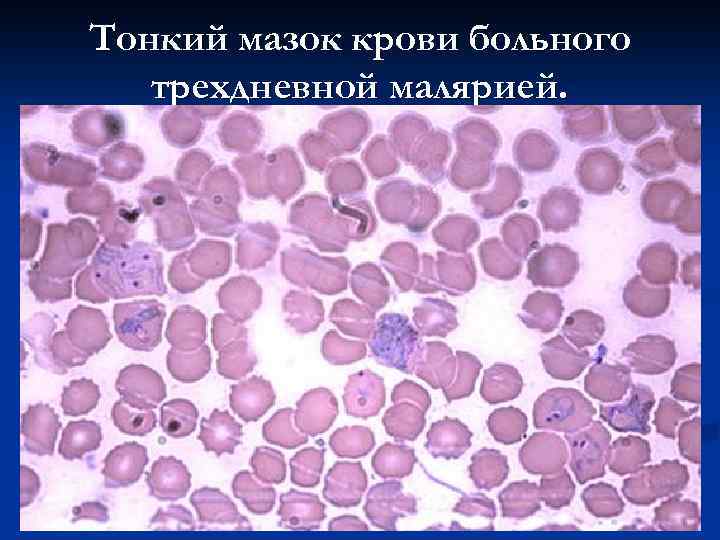
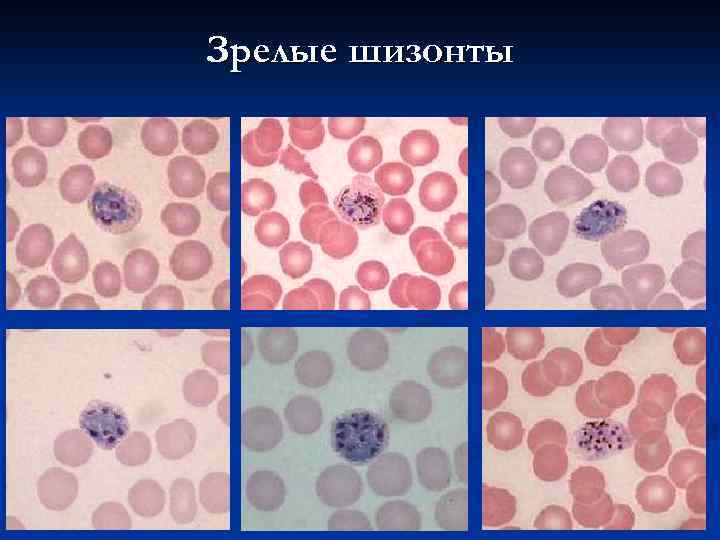

лекция 2 паразитические протисты.pptx
- Количество слайдов: 145
 Лекция 1 Паразитические простейшие
Лекция 1 Паразитические простейшие
 Простейшие –организмы, состоящие из одной клетки. Однако клетка эта выполняет функции целого организма.
Простейшие –организмы, состоящие из одной клетки. Однако клетка эта выполняет функции целого организма.
 Размеры простейших чаще всего лежат в пределах 50 -150 микрон. Самые мелкие достигают 13 мкм, а самые крупные – несколько сантиметров.
Размеры простейших чаще всего лежат в пределах 50 -150 микрон. Самые мелкие достигают 13 мкм, а самые крупные – несколько сантиметров.
 Форма тела простейших
Форма тела простейших
 Простейшие – эукариотические (ядерные) организмы.
Простейшие – эукариотические (ядерные) организмы.
 Форма ядер
Форма ядер
 Ядерный дуализм инфизорий Макронуклеус Микронуклеус
Ядерный дуализм инфизорий Макронуклеус Микронуклеус
 Ядро окружено цитоплазмой, в состав которой входят различные органеллы – части клетки, выполняющие функции органов и систем органов многоклеточных организмов.
Ядро окружено цитоплазмой, в состав которой входят различные органеллы – части клетки, выполняющие функции органов и систем органов многоклеточных организмов.
 Эктоплазма и эндоплазма эктоплазма
Эктоплазма и эндоплазма эктоплазма
 Известковые раковины фораминифер
Известковые раковины фораминифер
 Хитиновая раковина арцеллы
Хитиновая раковина арцеллы
 Агглютинированные раковины амеб - диффлюгий
Агглютинированные раковины амеб - диффлюгий
 Опорные образования Иглы у радиолярии Аксостиль у трихомонады
Опорные образования Иглы у радиолярии Аксостиль у трихомонады
 Органеллы движения: псевдоподии (у амеб).
Органеллы движения: псевдоподии (у амеб).
 Жгутики (лейшмании, лямблии)
Жгутики (лейшмании, лямблии)
 Реснички (инфузории)
Реснички (инфузории)
 Ундулирующая мембрана (трихомонады)
Ундулирующая мембрана (трихомонады)
 Органеллы прикрепления (фиксации). Стебельки у вортицелл.
Органеллы прикрепления (фиксации). Стебельки у вортицелл.
 Органеллы прикрепления (фиксации). Присасывательный диск у лямблий.
Органеллы прикрепления (фиксации). Присасывательный диск у лямблий.
 Сократительная вакуоль выполняет функции осморегуляции, выделения и дыхания.
Сократительная вакуоль выполняет функции осморегуляции, выделения и дыхания.
 Способы питания простейших. Гетеротрофное питание. Пищеварительные вакуоли.
Способы питания простейших. Гетеротрофное питание. Пищеварительные вакуоли.
 Способы питания простейших. Автотрофное питание.
Способы питания простейших. Автотрофное питание.
 Размножение простейших. Бесполое размножение ПРОСТОЕ ДЕЛЕНИЕ ПОЧКОВАНИЕ ШИЗОГОНИЯ
Размножение простейших. Бесполое размножение ПРОСТОЕ ДЕЛЕНИЕ ПОЧКОВАНИЕ ШИЗОГОНИЯ
 Размножение простейших. Половое размножение n ИЗОГАМИЯ n n n 2 n n Гаметы одинаковы АНИЗОГАМИЯ n 2 n n Гаметы неодинаковы 2 n
Размножение простейших. Половое размножение n ИЗОГАМИЯ n n n 2 n n Гаметы одинаковы АНИЗОГАМИЯ n 2 n n Гаметы неодинаковы 2 n
 Конъюгация
Конъюгация
 Инцистирование
Инцистирование
 Колония вольвокс
Колония вольвокс
 Дифференцировка клеток
Дифференцировка клеток
 Колониальные жгутиковые
Колониальные жгутиковые
 Паразитические простейшие – возбудители болезней человека и сельскохозяйственных животных.
Паразитические простейшие – возбудители болезней человека и сельскохозяйственных животных.
 Дизентерийная амеба (Entamoeba histolytica ). Паразит человека, вызывающий кишечный и внекишечный амебиаз.
Дизентерийная амеба (Entamoeba histolytica ). Паразит человека, вызывающий кишечный и внекишечный амебиаз.
 Малая вегетативная (просветная) форма Entamoeba histolytica в просвете кишки живет и питается бактериями
Малая вегетативная (просветная) форма Entamoeba histolytica в просвете кишки живет и питается бактериями
 Цисты Entamoeba histolytica способны сохраняться в окружающей среде до 2 недель
Цисты Entamoeba histolytica способны сохраняться в окружающей среде до 2 недель
 Большая вегетативная форма Entamoeba histolytica фагоцитированными с эритроцитами
Большая вегетативная форма Entamoeba histolytica фагоцитированными с эритроцитами
 Тканевые Entamoeba histolytica в подслизистой кишечника
Тканевые Entamoeba histolytica в подслизистой кишечника
 Амебный абсцесс печени.
Амебный абсцесс печени.
 Свищ при внекишечном амебиазе
Свищ при внекишечном амебиазе
 Кишечная амеба Entamoeba coli. Живет в просвете толстого отдела кишечника человека. Считается непатогенной.
Кишечная амеба Entamoeba coli. Живет в просвете толстого отдела кишечника человека. Считается непатогенной.
 Вегетативная форма (трофозоит) Entamoeba coli
Вегетативная форма (трофозоит) Entamoeba coli
 Цисты Entamoeba coli , содержащие 8 ядер Проходящий свет Фазовый контраст
Цисты Entamoeba coli , содержащие 8 ядер Проходящий свет Фазовый контраст
 Амеба Гартманна Entamoeba hartmanni. Живет в просвете толстого отдела кишечника человека. Считается непатогенной.
Амеба Гартманна Entamoeba hartmanni. Живет в просвете толстого отдела кишечника человека. Считается непатогенной.
 Амеба Гартманна Entamoeba hartmanni.
Амеба Гартманна Entamoeba hartmanni.
 Амеба Бючли Iodamoeba buetschlii Живет в просвете толстого отдела кишечника человека. Считается непатогенной.
Амеба Бючли Iodamoeba buetschlii Живет в просвете толстого отдела кишечника человека. Считается непатогенной.
 Iodamoeba buetschlii. Трофозоит.
Iodamoeba buetschlii. Трофозоит.
 Iodamoeba buetschlii. Трофозоит.
Iodamoeba buetschlii. Трофозоит.
 Iodamoeba buetschlii. Цисты.
Iodamoeba buetschlii. Цисты.
 Амеба карликовая Endolimax nana Живет в просвете толстого отдела кишечника человека. Считается непатогенной.
Амеба карликовая Endolimax nana Живет в просвете толстого отдела кишечника человека. Считается непатогенной.
 Трофозоиты Endolimax nana
Трофозоиты Endolimax nana
 Трофозоит Endolimax nana
Трофозоит Endolimax nana
 Цисты Endolimax nana
Цисты Endolimax nana
 Ротовая амеба Entamoeba gingivalis. Часто живет в ротовой полости человека, питается бактериями и не вызывает какихлибо патологических изменений. Цист не образует.
Ротовая амеба Entamoeba gingivalis. Часто живет в ротовой полости человека, питается бактериями и не вызывает какихлибо патологических изменений. Цист не образует.
 Entamoeba gingivalis
Entamoeba gingivalis
 Entamoeba gingivalis
Entamoeba gingivalis
 Entamoeba gingivalis
Entamoeba gingivalis
 Диентамеба Dientamoeba fragilis Живет в просвете толстого отдела кишечника человека. Считается непатогенной.
Диентамеба Dientamoeba fragilis Живет в просвете толстого отдела кишечника человека. Считается непатогенной.
 Dientamoeba fragilis
Dientamoeba fragilis
 Бластоцистис Blastocystis hominis. До недавнего времени считался непатогенным. Присутствие его в кишечнике иногда приводит к аллергическим реакциям и различным расстройствам ЖКТ.
Бластоцистис Blastocystis hominis. До недавнего времени считался непатогенным. Присутствие его в кишечнике иногда приводит к аллергическим реакциям и различным расстройствам ЖКТ.
 Blastocystis hominis
Blastocystis hominis
 Blastocystis hominis
Blastocystis hominis
 Акантамебы и неглерии. Свободноживущие амебы, способные поражать человека при ослаблении его иммунитета
Акантамебы и неглерии. Свободноживущие амебы, способные поражать человека при ослаблении его иммунитета
 Акантамебы в смыве из глаза.
Акантамебы в смыве из глаза.
 Акантамебный кератит.
Акантамебный кератит.
 Поражение кожи при инвазии Naegleria fowleri.
Поражение кожи при инвазии Naegleria fowleri.
 Лямблии (Lamblia intestinalis ). Паразитируют в тонкой кишке человека и многих животных. Вызывают лямблиоз (жиардиаз).
Лямблии (Lamblia intestinalis ). Паразитируют в тонкой кишке человека и многих животных. Вызывают лямблиоз (жиардиаз).
 Трофозоиты Lamblia intestinalis
Трофозоиты Lamblia intestinalis
 Цисты лямблий.
Цисты лямблий.
 Трипаносомы (Trypanosoma )– возбудители заболеваний человека и животных. Переносчиками паразитов служат, как правило, кровососущие двукрылые.
Трипаносомы (Trypanosoma )– возбудители заболеваний человека и животных. Переносчиками паразитов служат, как правило, кровососущие двукрылые.
 Муха це-це (Glossina – переносчик ) возбудителей различных трипаносомозов в Африке.
Муха це-це (Glossina – переносчик ) возбудителей различных трипаносомозов в Африке.
 Trypanosoma rhodesiense человека, в крови страдающего сонной болезнью .
Trypanosoma rhodesiense человека, в крови страдающего сонной болезнью .
 Терминальная стадия сонной болезни .
Терминальная стадия сонной болезни .
Trypanosoma congolense лошади. У в крови домашних животных вызывает болезнь «нагана»
Trypanosoma congolense лошади. У в крови домашних животных вызывает болезнь «нагана»
 Во многих странах Африки, Средней, Южной и Юго-Восточной Азии, а так же Южной Америки широко распространена болезнь домашних животных - «сурра» (су-ауру), возбудителем которой служит Тrypanosoma evansi , а механическими переносчиками – слепни, мухи-жигалки, комары.
Во многих странах Африки, Средней, Южной и Юго-Восточной Азии, а так же Южной Америки широко распространена болезнь домашних животных - «сурра» (су-ауру), возбудителем которой служит Тrypanosoma evansi , а механическими переносчиками – слепни, мухи-жигалки, комары.
 Тrypanosoma evansi в крови коровы
Тrypanosoma evansi в крови коровы
 Триатомовый клоп – переносчик возбудителей американского трипаносомоза (болезни Чагаса).
Триатомовый клоп – переносчик возбудителей американского трипаносомоза (болезни Чагаса).
 Трипомастиготы Тrypanosoma cruziкрови в
Трипомастиготы Тrypanosoma cruziкрови в
 Эпимастиготы Тrypanosoma cruzi
Эпимастиготы Тrypanosoma cruzi
 Амастиготы Тrypanosoma cruziсердечной мышце в
Амастиготы Тrypanosoma cruziсердечной мышце в
 Trypanosoma equiperdum вызывают случную болезнь лошадей и передаются половым путем.
Trypanosoma equiperdum вызывают случную болезнь лошадей и передаются половым путем.
 Трипаносомы в крови северного кожанка
Трипаносомы в крови северного кожанка
 Лейшмании (Leishmania ). Внутриклеточные паразиты млекопитающих. Возбудители кожных и висцеральных лейшманиозов, распространенных в странах Европы, Азии, Африки и Америки. Специфические переносчики – москиты.
Лейшмании (Leishmania ). Внутриклеточные паразиты млекопитающих. Возбудители кожных и висцеральных лейшманиозов, распространенных в странах Европы, Азии, Африки и Америки. Специфические переносчики – москиты.
 Москит Phlebotomus – переносчик лейшманий.
Москит Phlebotomus – переносчик лейшманий.
 Лептомонады (промастиготы) лейшманий из тела москита
Лептомонады (промастиготы) лейшманий из тела москита
 Две амастиготы в макрофаге.
Две амастиготы в макрофаге.
 Кала-азар (висцеральный лейшманиоз). Возбудитель – Leishmania donovan. Увеличение печени и селезенки у больных детей.
Кала-азар (висцеральный лейшманиоз). Возбудитель – Leishmania donovan. Увеличение печени и селезенки у больных детей.
 Кала-азар (висцеральный лейшманиоз). Возбудитель – Leishmania donovani. Увеличение селезенки.
Кала-азар (висцеральный лейшманиоз). Возбудитель – Leishmania donovani. Увеличение селезенки.
 Пендинская язва (кожный лейшманиоз). Возбудитель – Leishmania tropica.
Пендинская язва (кожный лейшманиоз). Возбудитель – Leishmania tropica.
 Пендинская язва (Кожный лейшманиоз). Возбудитель – Leishmania tropica.
Пендинская язва (Кожный лейшманиоз). Возбудитель – Leishmania tropica.
 Трихомонада мочеполовая Trichomonas vaginalis. Паразитирует на слизистых оболочках мочеполовой системы человека, вызывая воспалительные процессы. Цист не образует. Трихомоноз передается половым путем.
Трихомонада мочеполовая Trichomonas vaginalis. Паразитирует на слизистых оболочках мочеполовой системы человека, вызывая воспалительные процессы. Цист не образует. Трихомоноз передается половым путем.
 Trichomonas vaginalis.
Trichomonas vaginalis.
 Trichomonas vaginalis.
Trichomonas vaginalis.
 Трихомонада коровы Trichomonas foetus. Паразитирует на слизистых оболочках мочеполовой системы крупного рогатого скота, вызывая воспалительные процессы. Цист не образует. Передается половым путем.
Трихомонада коровы Trichomonas foetus. Паразитирует на слизистых оболочках мочеполовой системы крупного рогатого скота, вызывая воспалительные процессы. Цист не образует. Передается половым путем.
 Trichomonas. foetus
Trichomonas. foetus
 Кишечные трихомонады родов Tritrichomonas. Pentatrichomonas и Живут в ротовой полости и в толстом отделе кишечника человека и животных. Считаются непатогенными.
Кишечные трихомонады родов Tritrichomonas. Pentatrichomonas и Живут в ротовой полости и в толстом отделе кишечника человека и животных. Считаются непатогенными.
 Трихомонады из кишечника мыши
Трихомонады из кишечника мыши
 Трихомонады из кишечника мыши
Трихомонады из кишечника мыши
 Хиломастикс Chilomastix mesnili Обитает в слепой и толстой кишках человека. Практически непатогенен.
Хиломастикс Chilomastix mesnili Обитает в слепой и толстой кишках человека. Практически непатогенен.
 Chilomastix mesnili. Трофозоиты.
Chilomastix mesnili. Трофозоиты.
 Chilomastix mesnili. Циста.
Chilomastix mesnili. Циста.
 Малярия.
Малярия.
 Самка комара Anopheles – переносчик возбудителей малярии.
Самка комара Anopheles – переносчик возбудителей малярии.
 Цикл развития плазмодия
Цикл развития плазмодия
 Эксфлагелляция микрогамет в желудке комара
Эксфлагелляция микрогамет в желудке комара
 Ооцисты на стенке кишечника комара
Ооцисты на стенке кишечника комара
 Шизонт малярийного плазмодия в тканях печени
Шизонт малярийного плазмодия в тканях печени
 Plasmodium vivax - возбудитель трехдневной малярии.
Plasmodium vivax - возбудитель трехдневной малярии.
 Время развития Pl. vivax Развитие в комаре при температуре 17 -30°С идет 8 -30 суток Тканевая шизогония в печени человека 8 суток Эритроцитарная шизогония 48 часов
Время развития Pl. vivax Развитие в комаре при температуре 17 -30°С идет 8 -30 суток Тканевая шизогония в печени человека 8 суток Эритроцитарная шизогония 48 часов
Тонкий мазок крови больного трехдневной малярией.
Тонкий мазок крови больного трехдневной малярией.
 Юные (кольцевидные) трофозоиты
Юные (кольцевидные) трофозоиты
 Зрелые (амебоидные) трофозоиты
Зрелые (амебоидные) трофозоиты
 Юные шизонты
Юные шизонты
Зрелые шизонты
Зрелые шизонты
 Гаметоциты
Гаметоциты
 Толстая капля крови больного трехдневной малярией
Толстая капля крови больного трехдневной малярией
 Гепатоспленомегалия при малярии
Гепатоспленомегалия при малярии
 Plasmodium falciparum возбудитель тропической малярии. Это заболевание часто приобретает злокачественное течение.
Plasmodium falciparum возбудитель тропической малярии. Это заболевание часто приобретает злокачественное течение.
 Время развития Pl. falciparum Развитие в комаре при температуре 20 -30°С идет 9 -23 суток Тканевая шизогония в печени человека 6 суток Эритроцитарная шизогония 48 часов
Время развития Pl. falciparum Развитие в комаре при температуре 20 -30°С идет 9 -23 суток Тканевая шизогония в печени человека 6 суток Эритроцитарная шизогония 48 часов
 Время развития Pl. ovale Развитие в комаре при температуре 25 -27°С идет13 -16 суток Тканевая шизогония в печени человека 9 суток Эритроцитарная шизогония 48 часов
Время развития Pl. ovale Развитие в комаре при температуре 25 -27°С идет13 -16 суток Тканевая шизогония в печени человека 9 суток Эритроцитарная шизогония 48 часов
 Pl. ovale отличается характерным видом пораженных эритроцитов, имеющих фестончатый край.
Pl. ovale отличается характерным видом пораженных эритроцитов, имеющих фестончатый край.
 Время развития Pl. malariae Развитие в комаре при температуре 20 -30°С идет 14 -30 суток Тканевая шизогония в печени человека 15 суток Эритроцитарная шизогония 72 часов
Время развития Pl. malariae Развитие в комаре при температуре 20 -30°С идет 14 -30 суток Тканевая шизогония в печени человека 15 суток Эритроцитарная шизогония 72 часов
 Pl. malariae отличается характерным видом зрелого шизонта, который имеет «розетки»
Pl. malariae отличается характерным видом зрелого шизонта, который имеет «розетки»
 Кокцидии – возбудители кокцидиозов молодняка сельскохозяйственных животных.
Кокцидии – возбудители кокцидиозов молодняка сельскохозяйственных животных.
 Незрелые ооцисты кокцидий.
Незрелые ооцисты кокцидий.
 Созревание ооцист кокцидий (спорогония)
Созревание ооцист кокцидий (спорогония)
 Шизогония кокцидий
Шизогония кокцидий
 Криптоспоридии (Cryptosporidium parvumпаразитируют в клетках ) эпителия кишки человека и при иммунодефиците вызывают тяжелое заболевание, которое может закончится смертью. Встречается также и у животных.
Криптоспоридии (Cryptosporidium parvumпаразитируют в клетках ) эпителия кишки человека и при иммунодефиците вызывают тяжелое заболевание, которое может закончится смертью. Встречается также и у животных.
 Ооцисты криптоспоридий (окраска по Цилю - Нильсену).
Ооцисты криптоспоридий (окраска по Цилю - Нильсену).
 Токсоплазма (Toxoplasma gondii ). Поражает широкий круг хозяев из типа Хордовых и локализуется в различных тканях. Окончательные хозяева – кошки.
Токсоплазма (Toxoplasma gondii ). Поражает широкий круг хозяев из типа Хордовых и локализуется в различных тканях. Окончательные хозяева – кошки.
 Токсоплазмы в макрофаге
Токсоплазмы в макрофаге
 КТ головного мозга. Церебральный токсоплазмоз у больного СПИДом.
КТ головного мозга. Церебральный токсоплазмоз у больного СПИДом.
 Положительная реакция при пробе на токсоплазмин
Положительная реакция при пробе на токсоплазмин
 Пироплазмы (Piroplasmidae )– возбудители заболеваний животных. Паразиты локализуются в клетках крови и некоторых других тканях. Переносчиками служат иксодовые клещи.
Пироплазмы (Piroplasmidae )– возбудители заболеваний животных. Паразиты локализуются в клетках крови и некоторых других тканях. Переносчиками служат иксодовые клещи.
 Иксодовые клещи – переносчики пироплазмидозов.
Иксодовые клещи – переносчики пироплазмидозов.
 «Гранатовые тела» Theileria клетках в печени.
«Гранатовые тела» Theileria клетках в печени.
 Babesia canisэритроцитах собаки. в
Babesia canisэритроцитах собаки. в
 Пироплазма коровы (Piroplasma bovis)
Пироплазма коровы (Piroplasma bovis)
 Саркоцисис (Sarcocystis ) Виды этого рода развиваются со сменой хозяев. Окончательные хозяева хищные млекопитающие, в кишечнике которых происходит половое размножение и образование ооцист. Промежуточные хозяева – нехищные млекопитающие, у которых паразиты локализуются в мышцах, образуя псевдоцисты.
Саркоцисис (Sarcocystis ) Виды этого рода развиваются со сменой хозяев. Окончательные хозяева хищные млекопитающие, в кишечнике которых происходит половое размножение и образование ооцист. Промежуточные хозяева – нехищные млекопитающие, у которых паразиты локализуются в мышцах, образуя псевдоцисты.
 Циста саркоцистиса в мышцах крысы
Циста саркоцистиса в мышцах крысы
 Мазок из цисты саркоцистиса
Мазок из цисты саркоцистиса
 Род Besnoitia Виды этого рода развиваются со сменой хозяев. Окончательные хозяева кошки и др. хищные, в кишечнике которых происходит половое размножение и образование ооцист. Промежуточные хозяева копытные и некоторые грызуны, у которых паразиты локализуются в клетках кожи, образуя псевдоцисты.
Род Besnoitia Виды этого рода развиваются со сменой хозяев. Окончательные хозяева кошки и др. хищные, в кишечнике которых происходит половое размножение и образование ооцист. Промежуточные хозяева копытные и некоторые грызуны, у которых паразиты локализуются в клетках кожи, образуя псевдоцисты.
 Псевдоцисты Besnoitia besnoti в коже быка
Псевдоцисты Besnoitia besnoti в коже быка
 Балантидий (Balantidium coli ). Паразитирует в кишечнике человека и свиньи. Иногда проникает в ткани кишечника, вызывая образование язв.
Балантидий (Balantidium coli ). Паразитирует в кишечнике человека и свиньи. Иногда проникает в ткани кишечника, вызывая образование язв.
 Трофозоиты Balantidium coli
Трофозоиты Balantidium coli
 Балантидии в мазке фекалий
Балантидии в мазке фекалий
 Балантидии стенке кишки.
Балантидии стенке кишки.
 Миксоспоридии.
Миксоспоридии.


